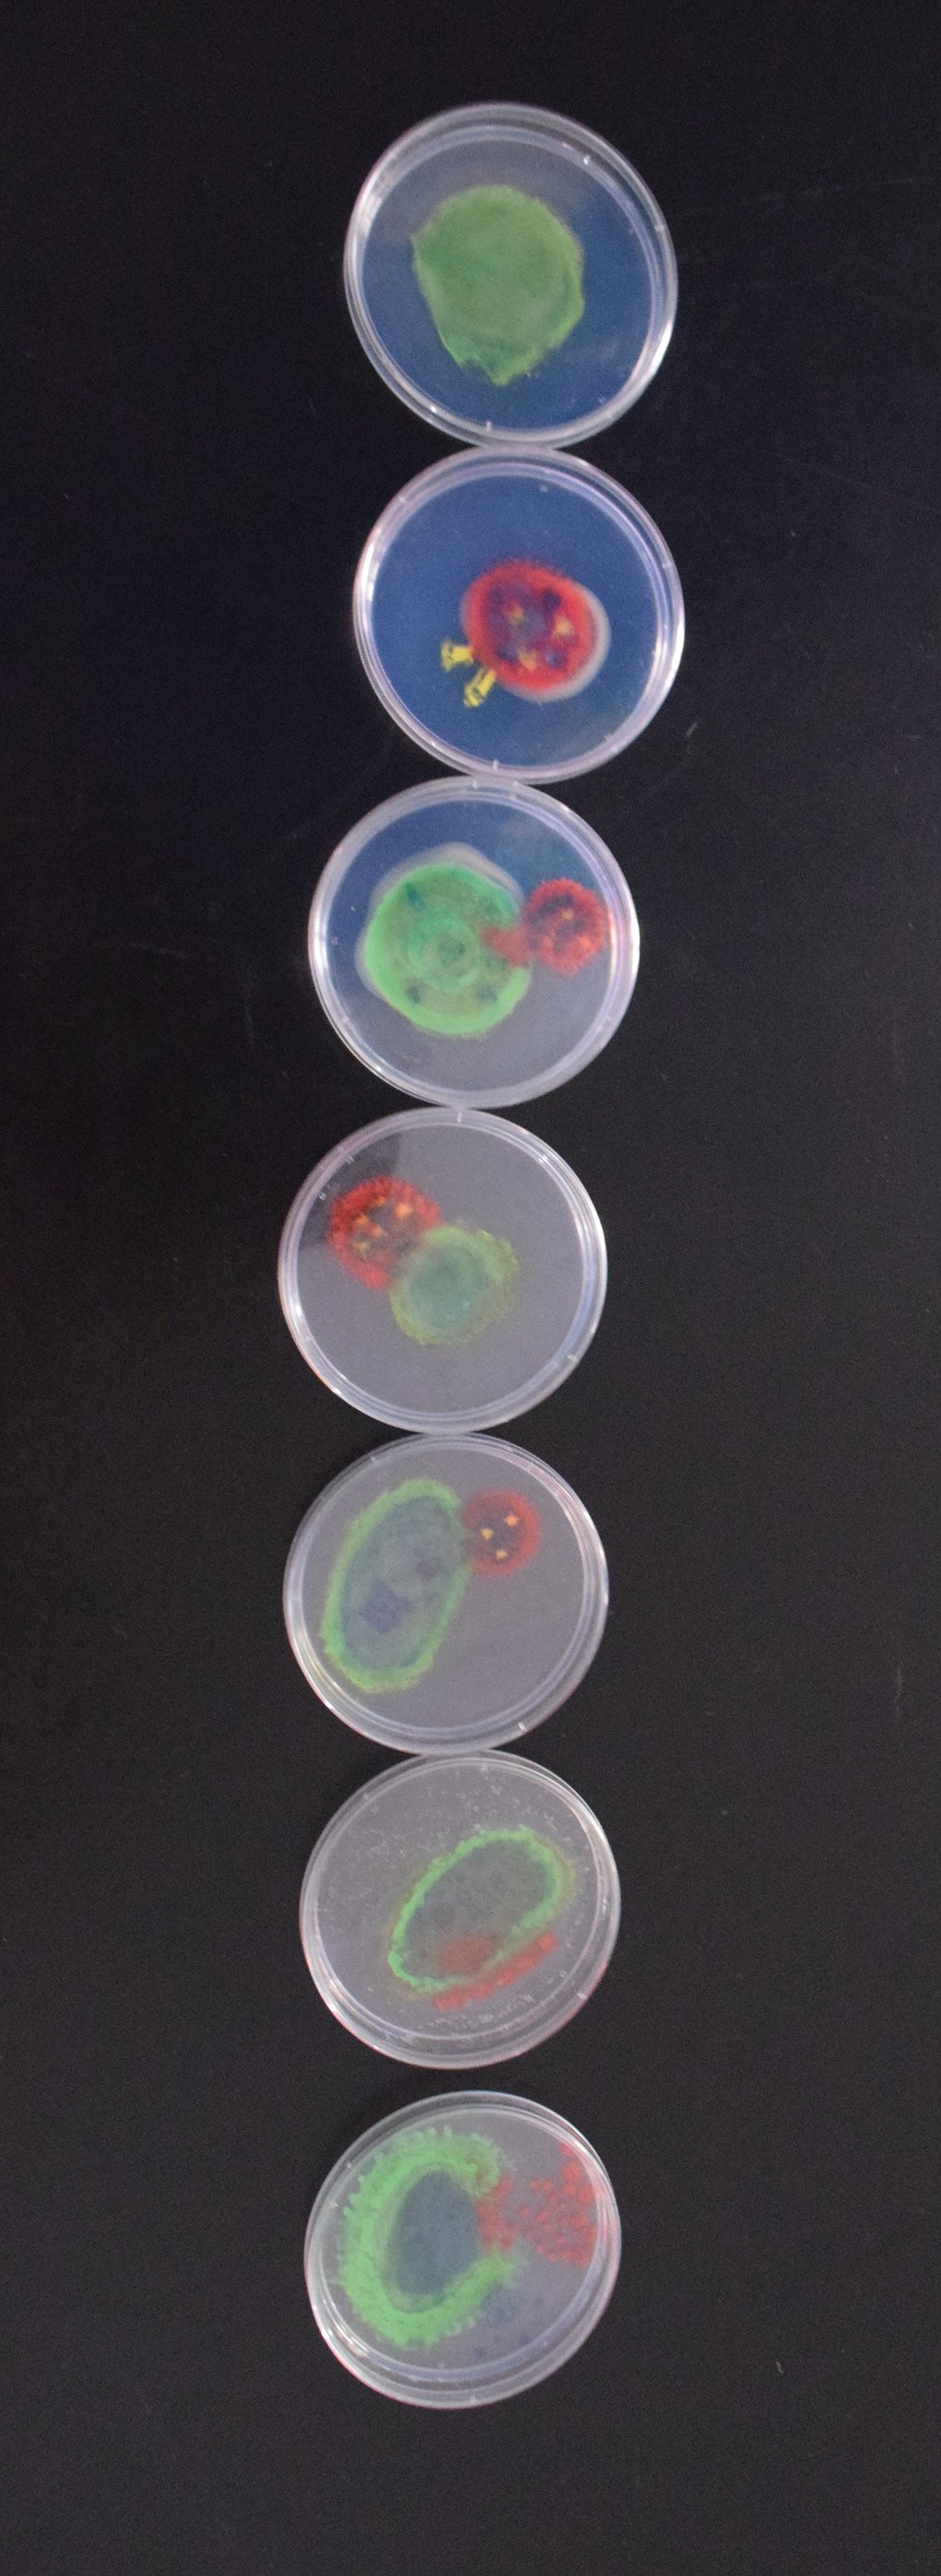

Building their way to nationals
NANCE BESTON | Hagadone News Network | UPDATED 11 months, 3 weeks AGO
EPHRATA – Ten sixth-grade Parkway Intermediate students, two advisors and a LEGO robot named Jeff will travel to New Jersey this week for the national LEGO Robotics championship. For a handful of the students, this is their first time on a plane, for others, their first time on the East Coast. For all of them, it will be their first time competing in the national LEGO championship.
“It was a really good experience working together because we all got to work as a team together. We do have some coders that code and people who worked on the innovation project, but we all share what we learned throughout the day,” Liliana Zaets said. “It was a really good experience because we learned a lot of things.”
The Parkway Pizzazz team competed in state Jan. 18 and won the “Breakthrough” award at state competition. The award entered them into a lottery to compete at nationals. The group was selected from the lottery and now they are on their way to the American Robotics Open Competition in New Jersey.
“It felt really good winning because we weren’t expecting to win, because we were going up against really good and really hard robotics teams,” Parkway Pizzazz member Kamberly Hurlburt said.
The competition has two parts: a research presentation with the theme “exploration” and the LEGO robotics presentation. The students have been working on both pieces twice a week since September, with students meeting daily closer to the competitions. For many of the students, this is their second year competing in LEGO robotics competitions.
The Ephrata School District did a send-off for the team Wednesday morning. The team had the opportunity to run through Parkway Intermediate and out the doors through a flag tunnel to their departing vehicles.
S.P.A.C.E Germs
“Hello, we are C.O.R.A.L., also known as the Cooperative, Organized Researchers that Are Luminous,” Isabelle Darby said as she opened their presentation. “Because we are bright and sparkly, we created S.P.A.C.E Germs to save our oceans from invasive algal blooms that detriment our economy.”
Hailey Forrest explained that a problem they found is that coral is dying because there are too many algae or cyanobacteria. Forrest said that the cyanobacteria produce a lot of oxygen during photosynthesis, which rises and floats away. As a result, oxygen levels in the ocean are lower than preferred.
“We began researching what caused coral to die, like benzene in sunscreen,” Mabel Chamberlin said. “We realized coral died because of dead zones, possibly agricultural runoff. We then created a bacterial germ to attack the algae. We then realized it would be more effective to use a virus with a predator-and-prey relationship because there are less complications and setbacks. With more research, our project blossomed into what it is today.”
Students then spoke with San Diego State University professor Dr. Forest Rohwer, a researcher with the Department of Biology. Rohwer specializes in marine biology and specifically coral reefs.
“When the cyanobacteria photosynthesize, (they create) extra sugar that sinks to the coral,” Kamberly Hurlburt said. “The coral reefs then die, then the fish die too. When our coral reefs die, it affects everyone from fishermen who fish for a living to you.”
Kali Hurlburt explained that their solution is S.P.A.C.E. Germs, which stands for Super Powerful and Carefully Engineered Germs.
“S.P.A.C.E. Germs are genetically engineered cyanophages, a type of virus that kills cyanobacteria, stopping harmful algae blooms,” Kali Hurlburt said. “Because so many people depend on coral for food and money, this is very essential.”
Kali Hurlburt explained that they will explore dead zones in the ocean using the International Space Station.
“We would start by exploring, using visualization tools and then track the growing dead zones so we can use the Germs to solve the problem,” Kali Hurlburt said.
Darby said the S.P.A.C.E. Germs are bioengineered cyanophages that will kill the cyanobacteria by latching onto the cyanobacteria host cell. She said that Rohwer explained that the cyanophage then injects its DNA, which will rapidly replicate itself, into the host cell. Once mature, the cyanophages will burst from the host cell, killing the cyanobacteria in the process.
“There is a natural predator vs. prey control so the cyanobacteria will not all die in the ocean,” Darby said.
The students found an article by the National Institute of Health that proved their hypotheses, Chamberlin said.
The students decided to use the International Space Station as a testing point because the satellites will help with exploration and, with it being in space, they will be able to control all variables, including temperature, light, water pressure and nutrient content.
The students also made an example of an anaerobic chamber which the scientists in space would use for experiments. The students also wondered if by being in space the phage would replicate quicker.
“Since space provides an atmosphere with little to no oxygen content, the germs will kill the algae and we will monitor them,” Calista Trejo said. “The germs will not kill all the algae, only enough to keep the coral safe. This is due to the Laca Volterra dynamics, which means we would rely on predator-and-prey relationships. The phage is a predator, and the cyanobacteria are the prey. It would naturally eliminate itself because of a balance in nature.”
The students made two poster boards, both with infographics designed and researched by students. They also made a video discussing their project, which can be watched here: bit.ly/ParkwayPizzazz. The team also made a song using artificial intelligence and their information, which can be found here: bit.ly/ParkwayPizzazzSong.
LEGO
The second part of the competition involves the LEGO robot and a course with several challenges on which the students have been working all year. The robot, Jeff, who will be in his fifth competition, will have several assignments as the competition begins, including knocking things over, lifting flags, moving pieces and spinning things. All of these challenges have been coded by the team for the robot to handle.
For each challenge the students accomplish, they will receive points towards their total.
“It’s pretty chaotic. There’s a lot of people screaming; mostly you hear cheers. They take one team into a classroom with two judges, and then we have our board, and we have our script, and we tell them our presentation,” Makayla Pellam said. “We bring Jeff in on the board, and we tell a bunch of facts, and we do a robot presentation. There’s also coding.”
The students explained the judges walk around and see how the teams are doing with cooperation and sportsmanship.
“That’s where we came up with the line: ‘don’t forget your Chapstick,’ which is our code for ... be mature and show your core values,” Darby said. “Because the judges are the Chapstick and, instead of being like, ‘There’s a judge,’ you have to be low-key about it.”
The students scored around 200 points at state, but they have since added more things to their board in hopes of getting more points.
“I am confident that we can do this,” Zaets said. “We can do this and extra. Last year, we did a little bit extra. This year, we did a little bit extra, and I am feeling confident that we can do extra. If we mess up, we get three tries, so if we miss one, we can go back to them on our other try.”
In a mixture of paint and plastic, Parkway Pizzazz students made examples of how bioengineered cyanophages will kill the cyanobacteria by latching onto their host cell. The cyanophage will inject its DNA into the host cell which will rapidly replicate itself. Once mature, cyanophages will burst from the host cell, killing the cyanobacteria in the process.
In a mixture of paint and plastic, Parkway Pizzazz students made examples of how bioengineered cyanophages will kill the cyanobacteria by latching onto their host cell. The cyanophage will inject its DNA into the host cell which will rapidly replicate itself. Once mature, cyanophages will burst from the host cell, killing the cyanobacteria in the process.ARTICLES BY NANCE BESTON

‘Show up’
Local leaders say community voices shape schools, cities and trust
WARDEN — When Warden Mayor Rosaelia Martinez looked out over the audience at the April 28 Warden City Council meeting, she didn’t see empty seats. She saw neighbors. “First of all, before we start, I want to say thank you to all those that came to the meeting tonight,” Martinez said. “I know we are all busy people, and I really appreciate your input. Your time is valuable and we appreciate you being here.” That message – that showing up matters – was echoed by city and school leaders across the Columbia Basin, many of whom say public participation directly shapes decision-making, transparency and long‑term planning.

Warden council bans kratom, considers parking regulations
WARDEN — Warden City Council passed a kratom ban and special event permit Tuesday night. It also discussed its comprehensive plan update and an ordinance for parking regulations. Around 17 residents were in attendance, a fairly large showing for a Warden council meeting. “First of all, before we start, I want to say thank you to all those that came to the meeting tonight,” Mayor Rosaelia Martinez said. “I know we are all busy people, and I really appreciate your input because it really validates what a lot of people are hoping to achieve in the city. Thank you. Your time is valuable and we appreciate you being here.”

Columbia Basin Hospital nominates Allred for board
EPHRATA — The Columbia Basin Hospital received one application for a vacant seat on the Board of Commissioners for Public Hospital District No. 3. Dr. Lowell Allred has applied for the role. He was officially nominated for the role at the April 28 board of commissioners meeting. “Public notice of this nomination shall occur between April 29 and May 14, to allow time for registered voters residing in the hospital district to also submit nominees for the vacant position,” said Chief Executive Officer Rosalinda Kibby.


















